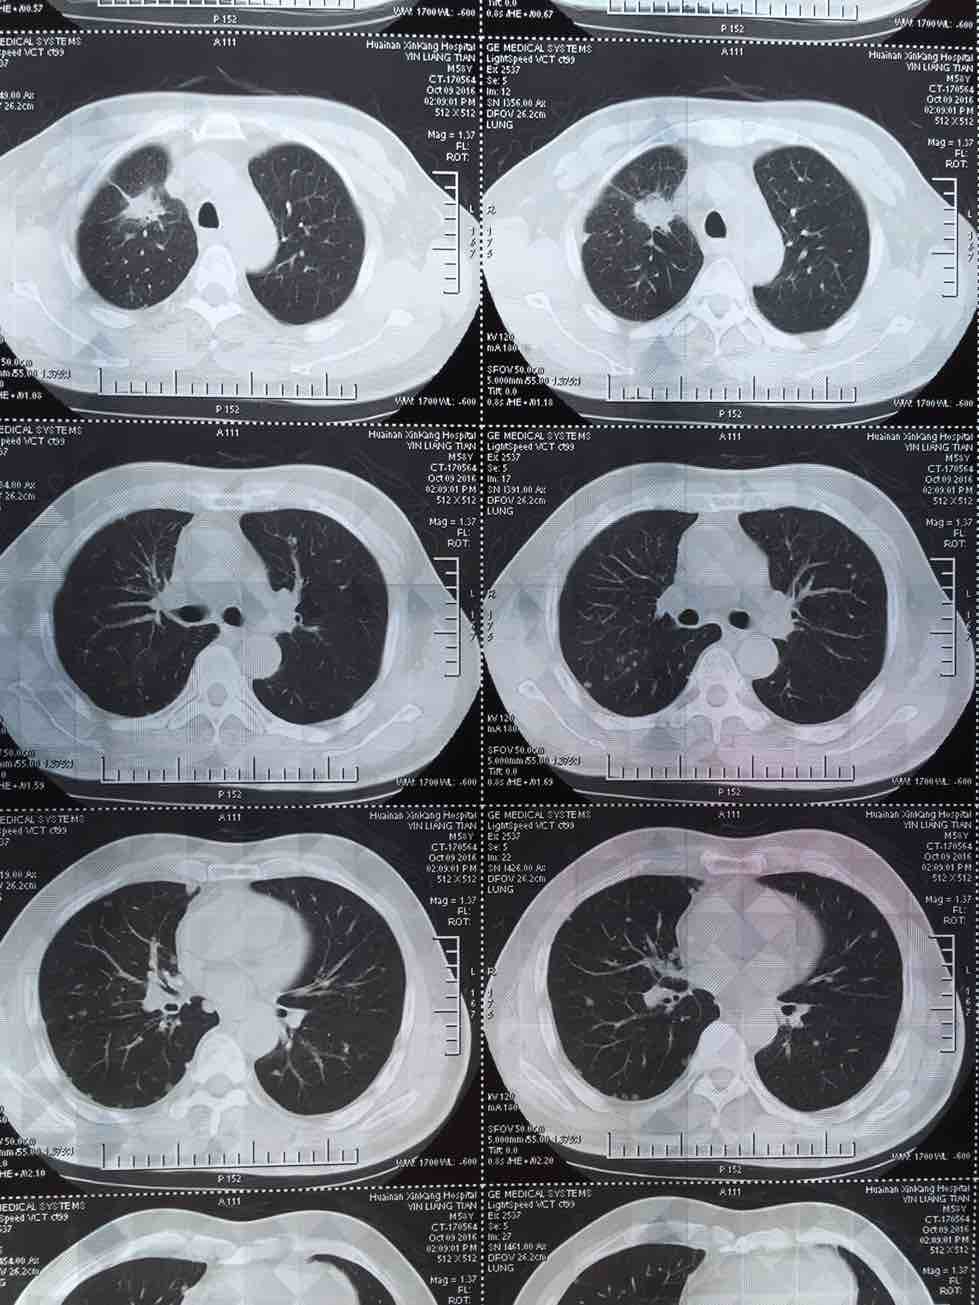
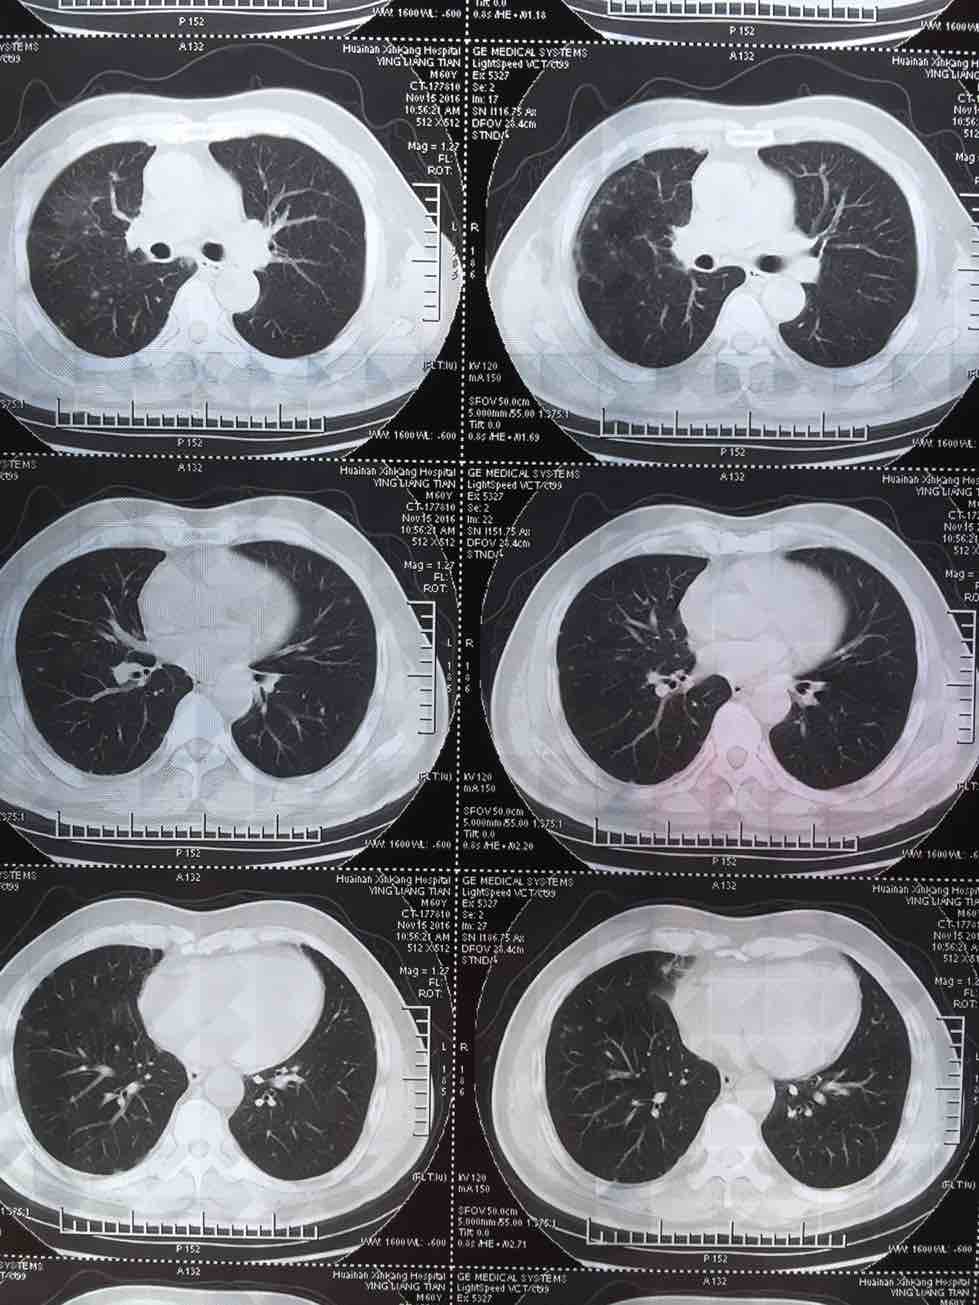

肺腺癌晚期治疗经验
我父亲今年一月份查出肺腺癌晚期伴两肺及腰椎骨盆转移,吉西他滨 顺铂两次,无效,后培美曲塞用了六次,最后一次今年7月25号出院,控制很好,期间主病兆放疗15次有所缩小,今年10月15号复查,两肺转移兆增多增大,紧接着做穿刺基因检测,结果野生型,顿时绝望,盲吃易瑞莎一个月,老天爷眷顾有效,病兆明显缩小或消失!!

收藏
回复(7)举报
参与评论
评论列表
按投票顺序
盲试易瑞莎有什么反应吗?我也是基因检测野生型!
举报
2016-11-19 09:11:21 有用(0)
回复(0)
你们很幸运!祝福!你们基因检测egfr野生型,kras有没有突变?
举报
2016-11-19 17:03:58 有用(0)
回复(0)
没什么反应,原来便秘的,反而便秘好了,自己说现在通畅多了!!心态很好,天天到公园和其他老年人打牌!我给他从印度带的易瑞沙!
举报
2016-11-19 15:48:22 有用(0)
回复(0)
有时候,基因检测有假阳性的!不一定靠谱!!
举报
2016-11-19 15:48:58 有用(0)
回复(0)
哦,是假阴性,有时假阴性率很高,必定基因检测很不是很成熟!
举报
2016-11-19 15:52:19 有用(0)
回复(0)
盲吃能中确实少见,可以写一篇case report了
举报
2016-11-20 01:11:10 有用(0)
回复(1)
相关推荐
热点推荐
暂无数据
























